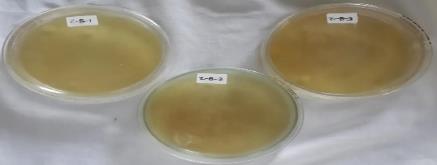
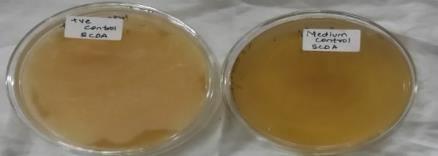
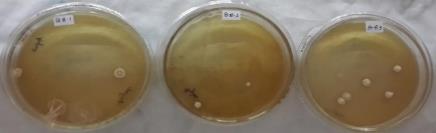
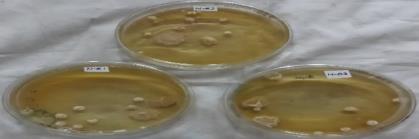
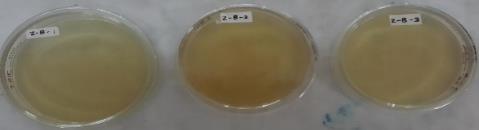
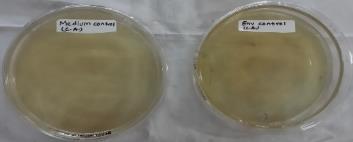
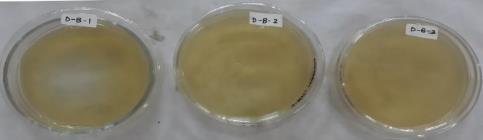
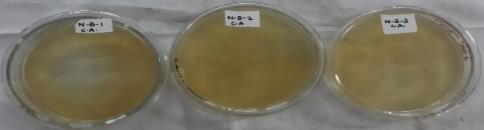
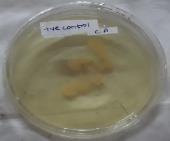
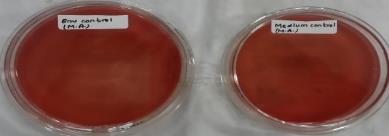
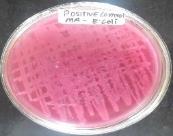
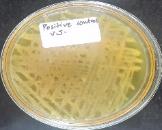

STANDARDISATION AND HPTLC METHOD DEVELOPMENT OF MARKETED AYURVEDIC FORMULATION–BALARISHTA
TABASSUM A. KHAN*1, ANJALI K. GOHEL1, RASHMI MALLYA1
SVKM’s Dr. Bhanuben Nanavati College of Pharmacy, Gate no. 1, SVKM Campus, V. M. Road, Vile Parle (W), Mumbai 400056, India
Email: tabassum.khan@bncp.ac.in
Received: 24 Nov 2015 Revised and Accepted: 25 Jan 2016
ABSTRACT
Objective: The present study aims to standardize four marketed brands of Balarishta, an Ayurvedic formulation viz. Baidyanath-Balarishta (BB), Dabur-Balarishta (DB), Zandu-Balarishta (ZB) and Nagarjuna-Balarishta (NB) with respect to their physicochemical (organoleptic properties, pH, specific gravity, total solid content, ethanol content, reducing and non-reducing sugar content), phytochemical and microbial parameters (total bacterial count, total fungal count and test for specific pathogens viz. P. aeruginosa, E. coli and S. aureus). It also aims to develop and validate a new highperformance thin layer chromatography (HPTLC) method for simultaneous determination of three major phytoconstituents present in Balarishta viz. withaferin A, gallic acid and ephedrine.
Methods: ‘Protocol for testing Ayurveda, Siddha and Unani medicines’ was used as a reference for conducting standardization experiments. HPTLC method was developed on Camag Linomat-5 using silica gel 60 GF254 as the stationary phase and Toluene: Chloroform: n-propanol: Ethanol: Formic acid (6: 3: 1: 2: 1, v/v/v/v/v) as the mobile phase. The analytical method validation studies were performed as per International Conference on Harmonization-Quality (ICH-Q2 (R1)) guidelines.
Results: The results of standardisation tests obtained were compared with specifications mentioned in ‘Ayurvedic Pharmacopoeia of India 2008 Volume 2, Part 2’ and a comparative data of each Balarishta formulation was generated for all the quality control parameters performed. A new, accurate, precise and robust HPTLC method was successfully developed with Retardation factor (Rf) of 0.17±0.02, 0.35±0.01 and 0.54±0.02 for ephedrine, gallic acid and withaferin A respectively.
Conclusion: The results of this research work will serve as a valuable quality tool for routine quality control analysis of Balarishta formulations.
Keywords: Balarishta, Standardisation, Withaferin A, Gallic acid, Ephedrine and HPTLC.
© 2016 The Authors. Published by Innovare Academic Sciences Pvt Ltd. This is an open access article under the CC BY license (http://creativecommons.org/licenses/by/4.0/)
INTRODUCTION
Ayurvedic knowledge originated in India more than 5,000 y ago and is often called the “Mother of All Healing” [1]. This ancient system of herbal medicines is being utilised by Indians and has also gained attention worldwide due to its long-term benefits in terms of overall wellness with no side effects. According to World Health Organization (WHO) estimates, the present demand for medicinal plants is about US $14 billion a year. About 88 % of the world’s inhabitants rely mainly on traditional medicine for their primary healthcare [2-5]. In spite of the long history of traditional use of herbal medicines, the number of reports of people experiencing negative effects, caused by the use of herbal drugs, has also been increasing. Poor quality of herbal medicines due to insufficient attention being paid to the quality assurance and control of these products is one of the major underlying reasons. Moreover, the practice of knowingly or unknowingly mixing adulterants in herbal formulations is rampant [6]. Due to the complex nature and inherent variability of the constituents of plant-based drugs, it is difficult to establish quality control parameters. The development of authentic methods which can reliably determine the quality of formulation as a whole and also of main phytoconstituents responsible for the activity is need of the hour. Asava-arishta is considered one of the most valuable therapeutics in Ayurvedic system of herbal medicines. A unique characteristic of these formulations is that they are prepared by fermentation of herbal decoction (in the case of arishta) and herbal infusion (in the case of asava) [7]. The fermentation process carried out by tannin-rich spores of Woodfordia fructicosa or Madhuka indica flowers and starch (in the form of jaggery, honey or sugar) results in the generation of alcohol in the product that acts as a preservative and also helps in the extraction of active principles. Thus, these formulations are known to possess enhanced therapeutic activity than the herbs alone and these are readily acceptable because of their sweet taste.
Table 1: Composition of Balarishta formulation [9]
S. No. |
Herbal composition |
Common name |
Plant part |
Quantity(kg) |
1. |
Sida cordifolia |
Bala |
Root |
4.8 |
2. |
Withania somnifera |
Ashwagandha |
Root |
4.8 |
3. |
Water |
Jala for decoction |
49.15 |
|
reduced to |
12.28 |
|||
4. |
Jaggery |
Guda |
14.4 |
|
5. |
Woodfordia fructicosa |
Dhataki |
Flower |
0.768 |
6. |
Ipomea digitata |
Payasya |
Sub. Root |
0.096 |
7. |
Ricinus communis |
Eranda |
Root |
0.096 |
8. |
Pluchea lanceolata |
Rasna |
Leaf |
0.048 |
9. |
Elettaria cardamomum |
Elaichi |
Seed |
0.048 |
10. |
Paederia foetida |
Prasarini |
Whole plant |
0.048 |
11. |
Syzgyium aromaticum |
Lavanga |
Flower |
0.048 |
12. |
Vetiveria zizanioides |
Usira |
Root |
0.048 |
13. |
Tribulus terrestris |
Goksura |
Fruit |
0.048 |
Balarishta, belonging to the category of asava-arishta, is used as a medicament to improve immunity and to treat diseases like arthritis, neuralgia, hemiplegia and spondolysis [8]. The therapeutic effect of this formulation comes from the major herbs present viz. Withania somnifera (Ashwagandha) and Sida cordifolia (Bala). The formulation composition of Balarishta as given in Ayurvedic Pharmacopoeia of India is given in table 1 [9]. The quantity of each ingredient in all four marketed preparation is variable and is given in table 2 as per the composition mentioned in their labels.
Table 2: Composition of marketed Balarishta formulation
S. No. |
Herbal composition |
Common name |
Quantity (g/10 ml) |
|||
BB |
DB |
ZB |
NB |
|||
1. |
Sida cordifolia |
Bala |
1.366 |
2.3 |
3.846 |
1.953 |
2. |
Withania somnifera |
Ashwagandha |
1.366 |
2.3 |
3.846 |
1.953 |
3. |
Jaggery |
Guda |
4.1 |
6.9 |
- |
5.859 |
4. |
Sugar |
Sakara |
- |
- |
11.538 |
- |
5. |
Woodfordia fructicosa |
Dhataki |
0.218 |
0.368 |
0.576 |
0.312 |
6. |
Ipomea digitata |
Payasya, Kshiravidhari |
0.0273 |
0.046 |
0.0714 |
0.0392 |
7. |
Ricinus communis |
Eranda |
0.0273 |
0.046 |
0.0714 |
- |
8. |
Pluchea lanceolata |
Rasna |
0.0136 |
0.0229 |
0.0354 |
0.0392 |
9. |
Elettaria cardamomum |
Elaichi, Ela |
0.0136 |
- |
- |
0.0392 |
10. |
Paederia foetida |
Prasarini |
0.0136 |
0.0229 |
0.0354 |
0.0392 |
11. |
Syzgyium aromaticum |
Lavanga |
0.0136 |
0.0229 |
0.0354 |
- |
12. |
Vetiveria zizanioides |
Usira |
0.0136 |
0.0229 |
0.0354 |
0.0196 |
13. |
Tribulus terrestris |
Goksura |
0.0136 |
0.0229 |
0.0354 |
0.0196 |
14. |
sukshmaila |
- |
0.0229 |
0.0354 |
- |
|
15. |
panchaangulam |
- |
- |
- |
0.0392 |
|
16. |
devapushpam |
- |
- |
- |
0.0196 |
|
17. |
Water |
Jala |
qs |
qs |
Qs |
qs |
The present study aims to standardize four marketed Balarishta formulations viz. BB, DB, ZB and NB with respect to their physicochemical, photochemical and microbial parameters. It also aims to develop and validate HPTLC method for simultaneous identification and quantitative determination of three major phytoconstituents present in Balarishta viz. withaferin A, gallic acid and ephedrine.
MATERIALS AND METHODS
Materials
The marketed Balarishta formulations were procured from local shops in the Mumbai market. Withaferin A was purchased from Natural Remedies Pvt. Ltd., Bangalore, while ephedrine and gallic acid were purchased from Total Herb Solution Pvt. Ltd., Mumbai. A gift sample of Withaferin A was provided by Dr. Lal Hingorani, Director, Pharmanza Herbal Pvt. Ltd., Anand, Gujarat. The solvents and chemicals used in this research project were of analytical grade. Camag Linomat-5 HPTLC application system and Camag HPTLC densitometer were used for analytical method development and validation studies.
Physicochemical studies
Organoleptic properties
Balarishta formulations were evaluated for their organoleptic properties viz. odour, appearance and taste.
pH
The pH of each formulation was measured using a calibrated pH meter [10].
Specific gravity
The specific gravity of each formulation was determined in triplicate using 10 ml specific gravity bottles and the following formula [10]-
Specific gravity of liquid (formulation) = (weight of 10 ml of liquid ÷10) ÷ (weight of 10 ml of water ÷10)
Total solid content
The total solid content of each formulation was determined by taking 10 ml of the formulation in porcelain evaporating dish and heating it on an electric water bath at 60–70 °C followed by placing in an oven at 105 °C until a constant weight of residue was obtained [10].
Ethanol content
25 ml of each formulation was taken in a 500 ml round bottom flask, diluted with 150 ml of distilled water and was attached to distillation unit after adding few porcelain pieces. It was distilled and not less than 90 ml of distillate was collected in 100 ml volumetric flask and diluted to volume with distilled water. The relative density of this solution was determined and the alcohol content was reported by comparing its value with the table mentioned in Indian Pharmacopoeia 2014, volume 1 [11].
Reducing and non-reducing sugar content
This was determined by Lane Eymon’s method of titrimetric analysis using Fehling’s solution [12].
- Determination of Fehling’s factor: 1 g of sucrose was hydrolyzed by adding 1 ml of concentrated Hydrochloric acid (HCl) and volume was made up to 100 ml with water. This was kept for 24 h, followed by titration against Fehling’s solution (5 ml of each Fehling A and Fehling B solution) using methylene blue as indicator. Fehling factor was determined using following formula-
Fehling factor (for invert sugar) = (Titre × weight of sucrose (g)) ÷ 100
Percent reducing sugar (%w/v) = (Fehling factor × dilution factor × 100) ÷ (Average titre value (ml))
- Determination of total sugar content: 10 ml of formulation was hydrolysed by adding 1 ml of concentrated HCl and volume was made up to 100 ml with water. This was kept for 24 h, followed by titration against Fehling’s solution (5 ml of each Fehling A and Fehling B solution) using methylene blue as indicator in triplicate and the average titre value was used to calculate percent total sugar content using following formula-
Percent total sugar (%w/v) = (Fehling factor × dilution factor × 100) ÷ (Average titre value (ml))
- Determination of non-reducing sugar content: The non-reducing sugar content value was determined using following formula-<
Percent non-reducing sugar (%w/v) = (percent total sugar (%w/v))–(percent reducing sugar (%w/v))
Phytochemical evaluation
Phytochemical evaluation for the presence of plant secondary metabolites like alkaloids, glycosides, flavonoids, steroids, tannins and phenolics, carbohydrates and proteins in the methanolic extract of formulation residue was conducted using qualitative tests as mentioned in the standard text [13].
Microbial examination
This involved determination of total bacterial count, total fungal count and test for specific pathogens viz. P. aeruginosa, E. coli and S. aureus. Each of the microbial experiments was performed in a sterilized laminar air flow chamber. This experiment was performed in a sample taken from the newly opened bottle. The sample stock solution was prepared by taking 10 ml of formulation and making up the volume to 100 ml with Soyabean Casein Digest (SCD) broth. 1 ml of this stock solution was used as a test sample for all the microbial tests. Four control petri plates viz. medium control, diluent i.e. broth solution (negative) control, positive control (bacteria/fungus culture) and environment control were set for each experiment. For total bacterial count, the test and control samples were incubated in Soybean Casein Digest Agar (SCDA) medium at 35 °C for 2-3 d. For total fungal count, the test and control samples were incubated in Sabouraud Dextrose Agar (SDA) medium at 25 °C for 5-7 d. The test for the presence of specific pathogen viz. P. aeruginosa, E. coli and S. aureus were determined by its characteristic growth of green, pink and light yellow coloured colonies when incubated in characteristic Cetrimide agar, Mac Conkey agar and Vogel Johnson agar medium respectively at 35 °C for 2-3 d [10].
HPTLC method development
Development and optimisation of mobile phase
A series of mobile phase systems reported for individual determination of ephedrine, gallic acid and withaferin A were explored in order to achieve good resolution of the selected phytoconstituents. However, modification in mobile phase was required as none of these trials were successful in resolving all three of them.
Preparation of sample
Balarishta formulation was heated on an electric water bath at 60-70 °C to evaporate the self-generated alcohol and obtain a residue. 10-12 grams of this residue was dissolved in around 40 ml of water [Residue in water-(R+H2O)] and transferred in 250 ml separating funnel. This solution was extracted with ethyl acetate (50 ml × 3 times) so as to extract withaferin A and gallic acid from the residue. For extraction of ephedrine, each formulation residue except for DB was made alkaline by adding around 40 ml of 0.1 N Sodium hydroxide (NaOH) [Residue in NaOH-(R+NaOH)], till the pH of sample reached 10-11 value. For DB, 40 ml of 1 N NaOH was required to make it alkaline (pH 10-11). The ethyl acetate fractions of each residue, both (R+H2O) and (R+NaOH) samples were collected separately and filtered through Whatmann filter paper.
The filtrate was subjected to vacuum evaporation using Rotavap, to obtain the dried ethyl acetate fraction. This fraction was weighed and dissolved in ethyl acetate for further HPTLC analysis. This procedure was found to be the most suitable sample pre-treatment procedure for efficient extraction of the three markers. Fig. 1 gives a schematic representation of the optimised sample preparation procedure.

Fig.1:Scheme for sample preparation of the Balarishta formulations
Preparation of standard
The stock solutions of each of the three reference standards were prepared in methanol. Accurately measured quantity of each reference standard was dissolved in methanol to get 200 ppm, 100 ppm and 500 ppm stock solution of withaferin A, gallic acid and ephedrine respectively.
HPTLC method validation studies
The developed HPTLC method was validated as per ICH Q2 (R1) guidelines for the following parameters [14].
Linearity and range studies
The linearity was evaluated in the concentration range of 4-28 µg/band for ephedrine, 0.1-1 µg/band for gallic acid and 0.5-5 µg/band for withaferin A. Peak area versus concentration was subjected to least square linear regression analysis and the slope, intercept and regression value for the calibration were determined. From the calibration plot, the concentration range which gave linear correlation between the peak area and the applied concentration was determined.
Limit of detection (LOD) and limit of quantitation (LOQ) studies
The LOD and LOQ for each marker were determined using the following expression-
LOD = (3.3 × s) ÷ S and LOQ = (10 × s) ÷ S
Where, s is the standard deviation and S is the slope of the calibration curve.
Accuracy studies
Accuracy was evaluated through the percent recoveries of known amounts (80%, 100% and 120%) of each marker spiked on one sample solution. Percent recovery was calculated from the following equation-
Percent Recovery = (Practical recovery ÷ Theoretical recovery) × 100.
Precision studies
Ephedrine, gallic acid and withaferin A in the concentration of 20 µg/band, 0.4 µg/band and 2 µg/band respectively were applied seven times on three different plates and percent coefficient of variation (% CV) between the peak area values were calculated after repeating the same experiment three times in a day (intraday precision) and on three different days (interday precision).
Specificity studies
The method was checked for the presence of any interference peaks from diluent and mobile phase.
Robustness studies
Robustness studies were carried out with an intentional variation in two chromatographic parameters viz. mobile phase composition and solvent front distance to determine its influence on the Rf value, peak area and peak shape of each standard. The mobile phase composition was altered by±0.5 ml of each solvent while the solvent front distance was altered by±10 mm from the optimized value.
Quantitation of marker compounds
Ephedrine, gallic acid and withaferin A were selected as marker compounds for the Balarishta formulation, and the developed analytical method was used for the quantitative estimation of the same in the four marketed Balarishta formulations viz. BB, DB, ZB and NB.
RESULTS
Physicochemical studies
The results of all physicochemical tests are given in table 3.
Organoleptic properties
The Balarishta formulations were brown in colour, liquid with alcoholic odour and sweet taste. The ZB had very light brown muddy colour as compared to the other three brands.
pH
The pH of the four formulations was found to be within the specification range i.e. 3.4–4.6 given for Balarishta in Ayurvedic Pharmacopoeia of India [9].
Specific gravity
The specific gravity of the four formulations was found to be within the specification range i.e. 1.05–1.20 given for Balarishta in Ayurvedic Pharmacopoeia of India [9].
Total solid content
Two out of the four formulations viz. DB and NB were found to comply with the specification limit of total solid content for Balarishta i.e. Not Less Than (NLT) 22 %w/v as mentioned in Ayurvedic Pharmacopoeia of India [9].
Ethanol content
The four Balarishta formulations were observed to comply with the specification range of ethanol content for Balarishta i.e. 5-10 % as mentioned in Ayurvedic Pharmacopoeia of India [9].
Reducing and non-reducing sugar content
The four brands of Balarishta except NB were found to comply with the specification limit for reducing sugar content i.e. NLT 14 %w/v. However, for non-reducing sugar content, only DB and NB were found to comply with the specification limit i.e. Not More Than (NMT) 1 %w/v as mentioned in Ayurvedic Pharmacopoeia of India [9].
Phytochemical evaluation
The methanolic extract of formulation-residue was found to contain alkaloids, steroids, tannins and phenolics, carbohydrates and proteins in all the four formulations.
Microbial examination
All the Balarishta formulations under study were found to comply with the specification limit for total bacterial count i.e. NMT 1× 105Colony Forming Unit per ml (CFU/ml) and total fungal count i.e. NMT 1× 103CFU/ml as mentioned in the book ‘Protocol for testing Ayurveda, Siddha and Unani medicines’ [10]. P. aeruginosa and E. coli were absent in all four formulations. In the test for the presence of S. aureus, BB and NB showed the presence of characteristic light-yellow coloured bacterial growth. However, the red colour of Vogel Johnson agar medium didn’t turn yellow as observed in positive control petri plate. On performing gram staining of the bacterial growth observed in both the samples, gram-positive rod-shaped bacteria were observed in BB sample Petri plate while gram positive cocci-shaped bacteria were observed in NB sample Petri plate. As S. aureus is gram positive cocci-shaped bacteria, NB might contain these bacteria. The Petri plates of the total bacterial count and the total fungal count is depicted in fig. 2 while the Petri plates of specific pathogen experiments are depicted in fig. 3.
Optimised HPTLC method
The optimised chromatographic conditions for HPTLC method development and validation and the chromatogram observed by this method are given in table 4 and fig. 4 respectively.
HPTLC method validation studies
The summary of all HPTLC validation parameters results is given in table 5.
Linearity and range studies
A linear correlation of the peak area and analyte concentration was observed at a concentration range of 8 to 28 µg/band (r2 =0.995), 0.1 to 0.8 µg/band (r2 = 0.995) and 0.5 to 4 µg/band (r2= 0.993) for ephedrine, gallic acid and withaferin A respectively.
LOD and LOQ studies
The calculated LOD and LOQ values were found to be 0.05 µg/band, 0.003 µg/band, 0.01 µg/band and 0.16 µg/band, 0.009 µg/band, 0.038 µg/band for ephedrine, gallic acid and withaferin A respectively.
Accuracy studies
The developed method was accurate with average percent recoveries of 81.32%, 89.94% and 94.04% for ephedrine, gallic acid and withaferin A respectively. The results were calculated as shown in table 5.
Table 3:Physicochemical tests of Balarishta formulations
S. No. |
Test |
Specification |
Balarishta formulations* |
|||
BB |
DB |
ZB |
NB |
|||
1 |
pH |
3.4–4.6 |
3.82 (±0.00) |
4.16 (±0.00) |
3.97 (±0.00) |
4.44 (±0.00) |
2 |
Specific gravity |
1.05–1.20 |
1.1035 (±0.514) |
1.0801 (±0.633) |
1.0947 (±0.041) |
1.0606 (±0.200) |
3 |
Total solid content |
NLT 22%w/v |
23.95 (±0.945) |
17.77 (±1.682) |
29.67 (±0.611) |
18.23 (±1.179) |
4 |
Ethanol content |
5–10% v/v |
9.53 (±0.605) |
8.70 (±1.149) |
9.20 (±1.086) |
9.60 (±1.804) |
5 |
Reducing sugar content |
NLT 14%w/v |
20.32 (±2.340) |
15.82 (±1.823) |
21.73 (±0.00) |
13.51 (±0.00) |
6 |
Non-reducing sugar content |
NMT 1%w/v |
1.41 (±0.00) |
0.51 (±1.882) |
4.58 (±0.00) |
0.94 (±1.665) |
*mean (±Relative Standard Deviation), n = 3.
Total Bacterial Count–SCDA medium |
|

|


 > > |
Control petri plates |
|
Total Fungal Count-SDA medium |
|

|

|
Control petri plates |
|
Fig. 2: Photo documentation of Petri plates of total bacterial count and total fungal count
Test for P. aeruginosa using Cetrimide agar medium |
||

|

|
|
Control petri plates |
||
Test for E. coli using Mac conkey agar medium |
||

|

|
|
Control petri plates |
||
Test for S. aureus using vogel johnson agar medium |
||


  |

|
|
Control petri plates |
||
Fig. 3: Photo documentation of petri plates of specific pathogens
Table 4:Optimised HPTLC chromatographic conditions
HPTLC instrument |
CAMAG Linomat 5 |
Stationary phase |
Silica Gel 60 GF254 |
Mobile phase |
Toluene: Chloroform: n-propanol: Ethanol: Formic acid (6: 3: 1: 2: 1, v/v/v/v/v) |
Observed Rf values |
Ephedrine: 0.17±0.02, Gallic acid: 0.35±0.01, Withaferin A: 0.54±0.02 |
Bandwidth |
8 mm |
Saturation time |
No saturation |
Solvent front distance |
80 mm |
Detection lamp |
Deuterium |
Detection wavelength |
254 nm |
Table 5:Recovery study of ephedrine, gallic acid and withaferin A
S. No. |
Sample conc. (µg/band) |
Std. Spiked (µg/band) |
Peak Area of- |
Theoretical recovery (A+B)= C |
% Recovery (D*100/C) |
Avg. % recovery |
||
Std. in sample (A) |
Std (B) |
Spiked sample/Practical recovery (D) |
||||||
Ephedrine |
||||||||
1 |
100 |
12.8 |
1160.25 |
2282.25 |
2785.1 |
3442.5 |
80.903% |
81.32% |
2 |
100 |
16 |
1160.25 |
2738.5 |
3141.6 |
3898.75 |
80.57% |
|
3 |
100 |
19.2 |
1160.25 |
2873.2 |
3327.7 |
4033.45 |
82.50% |
|
Gallic acid |
||||||||
1 |
10 |
0.32 |
3002.85 |
1883.55 |
4985.1 |
4886.4 |
102.01% |
89.94% |
2 |
10 |
0.40 |
3002.85 |
2946.05 |
5159.6 |
5948.9 |
86.73% |
|
3 |
10 |
0.48 |
3002.85 |
3317.3 |
5124.05 |
6320.15 |
81.07% |
|
Withaferin A |
||||||||
1 |
10 |
1.6 |
1271.05 |
2977.65 |
4044.1 |
4248.7 |
95.18% |
94.04% |
2 |
10 |
2.0 |
1271.05 |
3644.55 |
4530.05 |
4915.6 |
92.15% |
|
3 |
10 |
2.4 |
1271.05 |
3956.55 |
4956.4 |
5227.6 |
94.81% |
|

Fig.4:Chromatogram of ephedrine, gallic acid and withaferin A at optimized chromatographic conditions
Precision studies
The developed method was found to be precise. The results of interday and intraday precision studies of all three standards are given in table 6.
Specificity studies
The method was found to be specific for ephedrine, gallic acid and withaferin A with no interference peak of diluents and mobile phase at the Rf position of markers.
Table 6: Summary of analytical method validation parameters
Parameters |
Ephedrine |
Gallic acid |
Withaferin A |
Linearity (Regression value) |
0.995 |
0.995 |
0.993 |
Range (µg/band) |
8-28 |
0.1-0.8 |
0.5-4 |
LOD (µg/band) |
0.05 |
0.003 |
0.01 |
LOQ (µg/band) |
0.16 |
0.009 |
0.038 |
Accuracy (% recovery) |
81.32% |
89.94% |
94.04% |
Precision-Intraday (%CV) |
1.541% |
1.069% |
0.794% |
Precision–Interday (%CV) |
1.482% |
1.043% |
0.825% |
Specificity for interference of diluent and mobile phase |
Specific |
Specific |
Specific |
Robustness for change in solvent front distance |
Robust |
Robust |
Robust |
Robustness studies
There was no change in resolution, but the Rf values of all three markers were shifted down with decrease in mobile phase volume of each solvent by 0.5 ml. The resolution was distorted with an increase in Rf value when mobile phase volume of each solvent was increased by 0.5 ml. The method was found to be robust with both increase and decrease in solvent front distance by±10 mm.
Quantitation of markers
The ethyl acetate fraction of both (R+H2O) and (R+NaOH) samples of all four brands of Balarishta viz. BB, DB, ZB and NB were prepared and developed along with markers as shown in fig. 5 and fig. 6 and their respective peak chromatograms in fig. 7 and fig. 8. From the densitometric data of these samples, percent content of withaferin A, gallic acid and ephedrine in each of the formulation was calculated, and the percent content is mentioned in table 7.

Fig.5:HPTLC fingerprint of BB, DB samples and three marker standards at 254 nm

Fig.6:HPTLC fingerprint of ZB, NB samples and three marker standards at 254 nm
DISCUSSION
Arishta preparations undergo major changes in terms of their physicochemical, phytochemical, microbial and compositional parameters during the long fermentation process-major step in arishta formulation. Vinothkanna A et al. (2014) have observed and recorded periodic changes in organoleptic and biochemical parameters of Balarishta during fermentation process [15]. It is equally essential to evaluate quality parameters of finished products as that of evaluating raw materials. Preliminary phytochemicals screening and antioxidant activity evaluation on one of locally available Balarishta formulation was carried out by Rajalakshmy MR et al. (2011) and concluded to observe good antioxidant property [16].
BB (R+H2O) |
BB (R+NaOH) |
 |
 |
DB (R+H2O) |
DB (R+NaOH) |
 |
 |
Fig. 7: Densitogram of BB, DB samples and three marker standards.
ZB (R+H2O) |
ZB (R+NaOH) |
 |
 |
NB (R+H2O) |
NB (R+NaOH) |
 |
 |
Fig.8:Densitogram of ZB, NB samples and three marker standards
Table 7:Quantitation of markers in the marketed balarishta formulations
S. No. |
Sample |
Percent content of (%w/v) |
||
Ephedrine |
Gallic acid |
Withaferin A |
||
1 |
BB |
0.56200 |
0.00836 |
0.04004 |
2 |
DB |
0.01143 |
0.00056 |
0.00208 |
3 |
ZB |
0.00111 |
0.00009 |
0.00045 |
4 |
NB |
0.02535 |
0.00029 |
0.00074 |
Spectroscopic method for standardization of Balarishta was performed by Vador N et al., (2012) which included determination of total phenolics, total flavonoids, total alkaloids and total saponins along with few physicochemical tests on one in-house preparation and two marketed formulations [17]. The result of this present study provides comparative quality assessment data of all four marketed Balarishta preparations with standards defined by Ayurvedic Pharmacopoeia of India. In order to corroborate the standardization, a novel HPTLC method was developed for simultaneous identification of three major phytoconstituents present in main herbs of Balarishta viz. ephedrine, withaferin A and gallic acid.
CONCLUSION
Standardisation of four different brands of an Ayurvedic formulation-Balarishta viz. BB, DB, ZB and NB was successfully carried out with respect to their physicochemical (organoleptic properties, pH, specific gravity, total solid content, total ethanol content, reducing and non-reducing sugar content), phytochemical and microbial parameters (total bacterial count, total fungal count and test for specific pathogens viz. P. aeruginosa, E. coli and S. aureus) and comparative data was generated. Also, a new, simple, accurate, precise and robust HPTLC method was successfully developed for the simultaneous determination of ephedrine, gallic acid and withaferin A in all four Balarishta formulations. This method was validated as per the ICH Q2 (R1) guidelines. This method can be used for routine analysis and standardisation of Balarishta and other formulations containing these phytoconstituents, thereby increasing the scientific validity and quality of these herbal formulations.
ACKNOWLEDGEMENT
The authors are thankful to Dr. Lal Hingorani, Director, Pharmanza herbal Pvt. Ltd., Anand, Gujarat for providing the gift sample of withaferin A.
CONFLICT OF INTERESTS
The authors have declared no conflict of interest.
REFERENCES
- Rastogi S. Building bridges between Ayurveda and modern science. Int J Ayurveda Res 2001;1:41-2.
- Kochhar SL. Tropical crops: A textbook of economy botany. 2nd ed. London: Macmillan Pub Ltd; 1981. p. 268–71.
- Legal status of traditional medicine, complementary/ alternative medicine: a worldwide review. Geneva: World Health Organization; 2001.
- Yadav NP, Dixit VK. Recent approaches in herbal drug standardisation. Int J Integr Biol 2008;2:195-203.
- Farnsworth NR, Akerele O, Bingel AS, Soejarto DD, Guo ZG. Medicinal plants in therapy. Bull World Health Organization 1985;63:965-81.
- Pushpangadan. WHO guidelines on good agricultural collection practices (GACP) for medicinal plants. Indian J Med Res; 2004.
- Sekar S, Mariappan S. Traditionally fermented biomedicines, arishtas and asavasfrom Ayurveda. Indian J Traditional Knowledge 2008;7:548-56.
- Hebbar JV. Ayurvedic medicine information. Available from:
http://ayurmedinfo.com/2011/06/29/balarishta-uses-side-effects-dose-and-side-effects/. [Last accessed on 20 Oct 2015]. - The Ayurvedic Pharmacopoeia of India. Volume-2. Part-2. Department of Ayush, Ministry of Health, India. 2008. Available from: http://herbalnet. healthrepository.org/bitstream/ 123456789/2076/8/MONOGRAPHS-%20API%20Part%202% 20VOL-2.pdf. [Last accessed on 20 Oct 2015].
- Protocol for testing ayurveda, siddha and unani medicines. Dept. of AYUSH, Ministry of Health and Family Welfare, Ghaziabad. http://www. researchgate.net/ publication/ 224944109_Protocol_for_Testing_of_ayurvedic_Siddha_and_Unani_medicines. [Last accessed on 20 Oct 2015].
- Indian Pharmacopoeia. Govt of India. Ministry of Health and Family Welfare. 7th ed. Vol. 1; 2014. p. 116-7.
- Lane JH, Eynon L. Volumetric determination of reducing sugars by means of Fehling's solution with methylene blue as internal indicator. J Soc Chem Ind London 1923;2:32-6.
- Khandelwal KR. Preliminary phytochemical screening. Practical Pharmacognosy-Techniques and experiments. 14th ed. Nirali Prakashan; 2005. p. 149-53.
- ICH Harmonised Tripartite Guideline-Validation of Analytical Procedures: Text and Methodology Q2 (R1). Available from http://www.ich.org/fileadmin/Public_Web_Site/ICH_Products/Guidelines/Quality/Q2_R1/Step4/Q2_R1__Guideline.pdf. [Last accessed on 20 Oct 2015].
- Annadurai V, Subbiah M, Soundarapandian S. Tracking the organoleptic and biochemical changes in the Ayurvedic polyherbal and native fermented traditional medicines: Balarishta and Chandanasava. Int J Pharm Pharm Sci 2014;6:521-6.
- Rajalakshmy MR, Sindhu A. Preliminary phytochemical screening and antioxidant activity of an ayurvedic formulation: balarishtam. Int J Res Ayur Pharm 2011;2:1645-7.
- Vador N, Vador B, Hole R. Simple spectrophotometric methods for standardizing Ayurvedic formulation. Indian J Pharm Sci 2012;74:161-3.